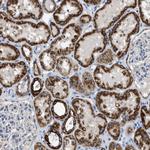
SLC25A13 Antibody in Immunohistochemistry (Paraffin) (IHC (P))

Search
Invitrogen
SLC25A13 Polyclonal Antibody
{{$productOrderCtrl.translations['antibody.pdp.commerceCard.promotion.promotions']}}
{{$productOrderCtrl.translations['antibody.pdp.commerceCard.promotion.viewpromo']}}
{{$productOrderCtrl.translations['antibody.pdp.commerceCard.promotion.promocode']}}: {{promo.promoCode}} {{promo.promoTitle}} {{promo.promoDescription}}. {{$productOrderCtrl.translations['antibody.pdp.commerceCard.promotion.learnmore']}}
产品信息
PA5-53887
种属反应
宿主/亚型
分类
类型
抗原
偶联物
形式
浓度
规格
纯化类型
保存液
内含物
保存条件
运输条件
RRID
产品详细信息
Immunogen sequence: KVALTKRADP AELRTIFLKY ASIEKNGEFF MSPNDFVTRY LNIFGESQPN PKTVELLSGV VDQTKDGLIS
Highest antigen sequence identity to the following orthologs: Mouse - 96%, Rat - 96%.
靶标信息
Citrin, also known as SLC25A13 (Solute carrier family 25 member 13), ARALAR2 or CTLN2, is a 675 amino acid multi-pass membrane protein that localizes to the inner membrane of the mitochondrion. Expressed in liver, pancreas, kidney, brain, heart and placenta, citrin functions as a calcium-dependent glutamate and aspartate carrier that is thought to play a role in the urea cycle. Citrin, a member of the mitochondrial carrier family, contains three Solcar repeats and four EF-hand domains through which it binds calcium. Defects in the gene encoding citrin are the cause of citrullinemia type 2 (CTLN2) and neonatal intrahepatic cholestasis due to citrin deficiency (NICCD). CTLN2 is an autosomal recessive disease that results from errors in the urea cycle and is characterized by neuropsychiatric symptoms such as loss of memory, seizures and coma. NICCD, a non-lethal disorder, occurs during infancy and is characterized by low birth weight, reduced bile flow, growth retardation and hepatic fibrosis.
仅用于科研。不用于诊断过程。未经明确授权不得转售。
篇参考文献 (0)
生物信息学
蛋白别名: ARALAR-related gene 2; aralar2; Calcium-binding mitochondrial carrier protein Aralar2; Citrin; citrullinemia type II; Electrogenic aspartate/glutamate antiporter SLC25A13, mitochondrial; Mitochondrial aspartate glutamate carrier 2; putative calcium-dependent mitochondrial carrier protein; solute carrier family 25 (aspartate/glutamate carrier), member 13; Solute carrier family 25 member 13; unnamed protein product
基因别名: AGC2; ARALAR2; CITRIN; CTLN2; NICCD; SLC25A13
UniProt ID: (Human) Q9UJS0
Entrez Gene ID: (Human) 10165